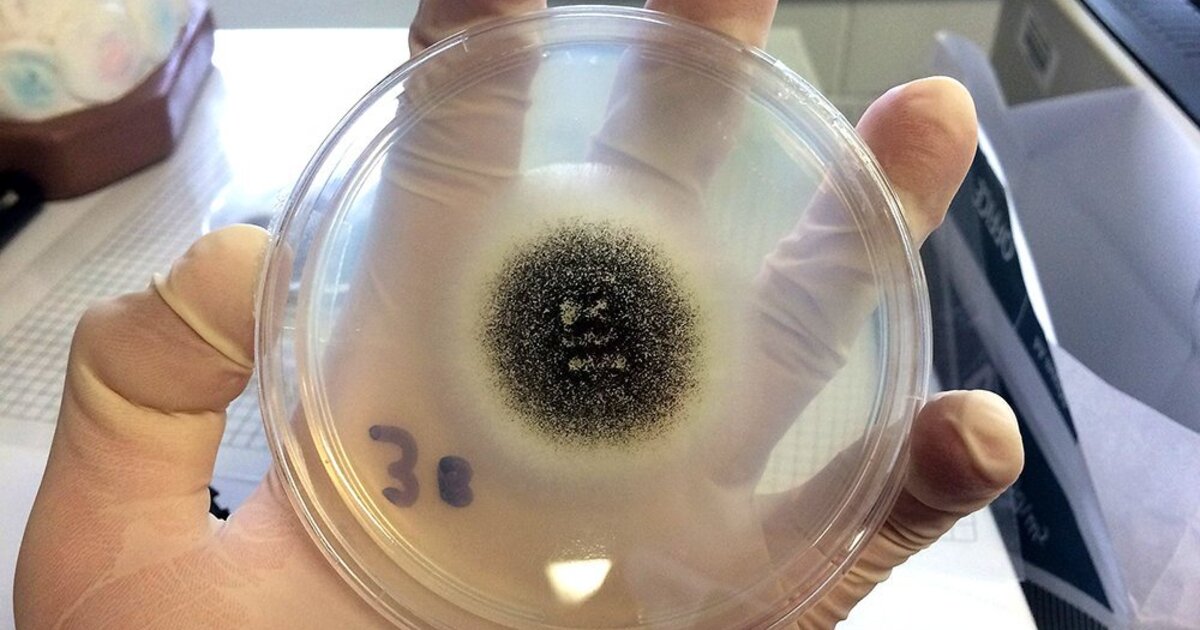
7998cbad2211f5df48f14643f6ba6f3e69a3cd02

Ученые: Плесень может вас видеть
Биологи исследовали отдельный вид цианобактерий. Они имеют круглую форму, и ученые подметили, что когда свет попадает на одну сторону бактерии, то вся бактерия начинает действовать как линза — преломляет свет и фокусирует его на противоположной стороне в одной точке. Специальные рецепторы улавливают источник этого света, и в итоге вся бактерия движется к нему с помощью специальных нитевидных отростков расположенных на ее теле.
Но удивляет другое. А именно, что и цианобактерим, и человеческий глаз скорее всего видят мир примерно одинаково. Как и изображения в человеческом глазу так и образ, увиденный бактерией, перевернут вверх ногами. Правда, в наших глазах изображения гораздо четче, и человеческий мозг еще и переворачивает картинку как надо.
© Ferra.ru
